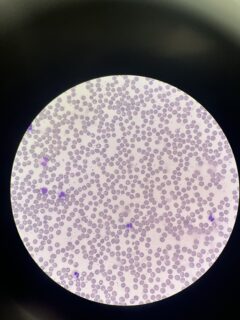

Recapping our Summer Conservation Intern Program
Over the summer, we hosted three veterinary students as part of our Summer Conservation Intern program. They worked alongside our veterinary and animal care teams to support three conservation programs here at Houston Zoo. Read more about each of our interns and the wildlife-saving work they helped with this summer.
Meet Sea Turtle Intern Dilmeet “Twinkle” Kaur
This summer, I served as the Sea Turtle Intern at the Houston Zoo through their Veterinary Summer Internship program. Under the mentorship of Dr. Kendra Bauer and with support from the entire veterinary clinic team, I worked closely with sea turtles in rehabilitation, learned about their care, and contributed to research that could shape future treatments. Their kindness, understanding, and eagerness to teach made a huge difference in my experience.
Working with sea turtles has been a dream of mine for as long as I can remember, and this summer truly felt like that dream came to life. Every day at the zoo was a gift, I woke up excited to learn something new. I gained hands-on experience feeding turtles oral meds and administering intramuscular and intravenous injections. Drawing blood from sea turtles was initially nerve-wracking because it’s a “blind stick,” but with guidance from the amazing vets and techs, I improved greatly. It’s one of the coolest things I’ve done in my vet journey so far. I also assisted with hook removal surgeries, observed radiographs, and helped with daily water quality and behavioral checks. One of the most powerful moments was witnessing a sea turtle release, watching a rehabilitated turtle return to the ocean after weeks of care was an emotional and inspiring reminder of why this work matters.
Beyond sea turtles, I spent time with other conservation species. I fed Houston toads crickets and learned about their behavior, anatomy, and physiology. I also assisted in husbandry and deworming of Attwater’s prairie chickens, gaining insight into the zoo’s role in protecting critically endangered species. One of the absolute highlights was spending a day with the elephants. I’ve always been fascinated by these majestic animals, and getting to see them up close was unforgettable. I learned a lot about their husbandry and even had the incredible opportunity to give one of the elephants a bath, an experience I’ll never forget. Another highlight was clinic days, where I worked with a variety of wildlife species. I drew blood from a copperhead, gave injections to a mongoose, and observed procedures on animals ranging from reptiles to large mammals. These experiences enhanced my hands-on skills and reinforced my passion for zoo and wildlife medicine. A major part of my summer was an independent research project on osteomyelitis treatment in sea turtles, focusing on the long-term use of oral clindamycin. I analyzed case data from multiple institutions to identify trends in antibiotic use and clinical outcomes. While much of this work was desk-based, it showed me how vital research is for the future of conservation medicine. Contributing even a small piece to improving sea turtle care has been deeply rewarding.
What made this summer truly special were the people. Every staff member, veterinarian, technician, and keeper I worked with was supportive, approachable, and enthusiastic about teaching. I’m leaving this internship feeling incredibly grateful, more confident in my path, and more excited than ever to pursue a career in zoo and wildlife medicine. I will always look back on this summer with joy, appreciation, and admiration for the animals, the work, and the people who made it all possible.
Meet APC Intern Maeve Rogers
This summer, I had the incredible opportunity to serve as the Atwater’s Prairie Chicken (APC) intern at the Houston Zoo! Twice a week, I commuted to NASA, where the APC facility is located, to assist with basic husbandry, deworming, and any medical treatments needed that day. While the veterinary medicine aspect was especially exciting, the most rewarding part was watching nearly 100 chicks grow into healthy adults ready to be released into the wild. Witnessing conservation efforts up close was truly inspiring—and to my surprise, I developed a real soft spot for birds, a group I hadn’t worked with before this summer.
In addition to the hands-on animal care, I had the chance to work on two research projects. The first was a retrospective study on Reticuloendotheliosis Virus (REV) in the zoo’s APC population over the last 12 years. I reviewed 120 necropsy records of birds that had tested positive, looking for trends in both clinical and subclinical cases. With the data I gathered, I hope to provide insights that can help guide future decisions about managing REV-positive birds.
My second project focused on the pharmacokinetics of meloxicam in APCs. Meloxicam is a key anti-inflammatory and pain-relief medication, and due to the prairie chickens’ clumsy nature, they often need all the help they can get! For this study, I collected blood samples from 40 birds-an experience that I absolutely loved. I tested both oral and injectable routes at a higher dose than previously studied, aiming to ensure that therapeutic blood levels were being reached.
This internship has taught me so much—not only about APCs but also about the broader field of zoo veterinary medicine. Getting to work with a variety of exotic species has been incredibly meaningful, and I’m deeply grateful for the experiences I had at the Houston Zoo. I hope to return one day as an extern or resident and continue exploring this challenging, rewarding career path!
Meet EEHV Intern Abi Hsu
I was three years old when I first discovered my vehement passion for proboscideans, and this early adoration has steadily evolved into the dream of becoming an elephant conservationist. Last summer, I was fortunate to participate in the incredible Houston Zoo conservation internship program. I spent most of my time in the Ling Lab with veterinarian and Epidemiology PhD student, Dr. Jennifer Yu, compiling serology data into a nationwide seroprevalence study. This summer, I had the privilege of returning to the Houston Zoo to continue studying elephant endotheliotropic herpesvirus (EEHV) under Dr. Christine Molter.
As the EEHV intern, much of my time was dedicated to conducting a case series on known EEHV6 viremias in African elephants. I will be spending next week with Dr. Paul Ling and his team at Baylor College of Medicine, performing an assay developed in the Ling lab for detection of anti-EEHV antibodies in serum. Serologic testing is integral to informing management strategies, identifying vaccine candidates, and conducting accurate risk assessments. With a steadfast determination to advance EEHV research, the Ling lab embodies the sentiment that there is always a path forward. To quote Dr. Ling, “who wouldn’t want to help save baby elephants?”
Another highlight of my summer has been assisting Rob Bernardy, Kristin Windle, and the rest of the amazing elephant care team with their daily responsibilities. Not only are the Houston Zoo elephant keepers experts in managing a large Asian elephant herd, but they are kind and altruistic. They seamlessly transition from maintaining enclosures to feeding, bathing, training, medicating, and collecting blood from their animals for weekly EEHV surveillance. They graciously engage with the community to bolster conservation efforts through education and outreach. I am inspired by their relentless commitment to elephant health and welfare.
Finally, I had the invaluable opportunity to learn from the Houston Zoo veterinarians, vet techs, clinic keepers, admin, and volunteers. The clinic staff never cease to impress me with their depth of knowledge, unremitting compassion for humans and animals alike, and profound willingness to support students. I was able to assist with exams and procedures on a dingo, pancake tortoise, capybara, red-lored amazon, and green sea turtle. I also reviewed elephant CBCs! I entered veterinary school with the hope of eventually making contributions in elephant conservation. In the two formative summers that I have spent at the Houston Zoo, I have come to understand the importance of research in enacting tangible change on a larger scale. There is no amount of gratitude that can fully encompass the impact that this one-of-a-kind community has had on me and my future. The people and animals of the Houston Zoo will always hold a special place in my heart!